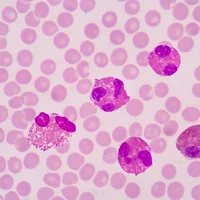
maladies-a-eosinophiles

Une allergie alimentaire est une réaction excessive du système immunitaire à une protéine alimentaire spécifique.
Types : il existe différents types d'allergies alimentaires, mais les huit allergènes alimentaires les plus courants sont :
- Les arachides.
- Les fruits à coque.
- Les crustacés.
- Les mollusques.
- Les œufs.
- Le lait.
- Le soja.
- Le blé.
Symptômes : les symptômes d'une allergie alimentaire peuvent varier en gravité, allant de légère à potentiellement mortelle.Les symptômes peuvent inclure :
- Des démangeaisons de la bouche.
- Des éruptions cutanées.
- Des nausées.
- Des vomissements.
- Des douleurs abdominales.
- Des diarrhées.
- Des difficultés respiratoires.
Causes : les causes d'une allergie alimentaire sont liées à une réaction excessive du système immunitaire aux protéines alimentaires. Certaines personnes peuvent avoir une prédisposition génétique à développer des allergies alimentaires.
Diagnostics : le diagnostic d'une allergie alimentaire implique un examen physique, une analyse des antécédents médicaux et des tests cutanés ou sanguins.
Complications : les complications possibles d'une allergie alimentaire incluent une anaphylaxie, qui est une réaction allergique sévère et potentiellement mortelle.
C'est pourquoi il est important de prendre les allergies alimentaires au sérieux et de suivre les recommandations de prévention et de traitement.
Traitements : le traitement de l'allergie alimentaire implique l'éviction de l'aliment allergène de l'alimentation, ainsi que la prise de médicaments pour soulager les symptômes en cas d'exposition accidentelle
Préventions : les mesures préventives comprennent :
- L'étiquetage des aliments.
- L'évitement des aliments potentiellement allergènes.
- La communication avec les autres, tels que les amis, la famille et les enseignants.
Note importante : les informations communiquées ci-dessus ne le sont qu’à titre informatif, elles ne peuvent en aucun cas constituer une base pour un diagnostic ou un traitement. En cas de symptômes ou de soupçons, il vous est vivement recommandé de vous rapprocher d’un professionnel de la santé habilité. Plus de 40.000 professionnels de la santé sont référencés sur notre plateforme, vous pouvez à tout moment consulter notre annuaire, prendre un rendez-vous au cabinet, à domicile ou en télé-consultation en un clic sur www.docteur360.com